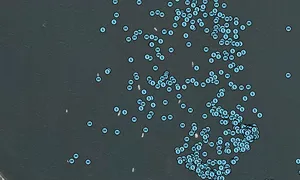

RELOAD 'N CHARGE!, MMSI: 367706670

Follow the journey
Images of RELOAD 'N CHARGE!
Journey statistics
Preferred harbour type
2026
17% marina
natural harbour 83%
2025
0% marina
natural harbour 100%
2024
33% marina
natural harbour 67%
2020
0% marina
natural harbour 100%
2016
50% marina
natural harbour 50%